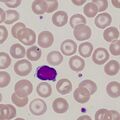
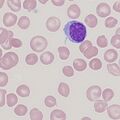
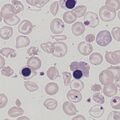

Uncategorised files
Showing below up to 50 results in range #401 to #450.
- SCP0.png 472 × 472; 44 KB
- SCP1.png 472 × 472; 77 KB
- SCP2.jpg 472 × 472; 46 KB
- SCP3.jpg 472 × 472; 71 KB
- SCP4.jpg 472 × 472; 69 KB
- SP0.png 472 × 472; 110 KB
- SP1.png 472 × 472; 125 KB
- SP2.jpg 472 × 472; 43 KB
- SP2A.jpg 472 × 472; 37 KB
- SP3.jpg 472 × 472; 72 KB
- SP4.jpg 472 × 472; 80 KB
- Schizontcartoon1.jpg 472 × 472; 60 KB
- Schizontcartoon2.jpg 472 × 472; 86 KB
- Schizontcartoon3.jpg 472 × 472; 113 KB
- Schizontcartoon4.jpg 472 × 472; 86 KB
- Schizontreal1.jpg 472 × 472; 46 KB
- Schizontreal2.jpg 472 × 472; 32 KB
- Schizontreal3.jpg 472 × 472; 114 KB
- Schizontreal4.jpg 472 × 472; 60 KB
- Schuf1.jpg 472 × 472; 54 KB
- Schuf2.jpg 472 × 472; 58 KB
- Schuf3.jpg 472 × 472; 56 KB
- Schuf4.jpg 472 × 472; 54 KB
- Schuffner1.jpg 472 × 472; 43 KB
- Species.jpg 472 × 472; 81 KB
- Species 2.jpg 472 × 472; 63 KB
- Species new.jpg 472 × 472; 73 KB
- St0.png 472 × 472; 57 KB
- St0A.png 531 × 531; 52 KB
- St1.png 472 × 472; 187 KB
- St2.jpg 472 × 472; 50 KB
- St3.jpg 591 × 591; 119 KB
- St4.jpg 606 × 640; 112 KB
- St5.jpg 532 × 537; 99 KB
- TC0.png 472 × 472; 87 KB
- TC1.png 472 × 472; 63 KB
- TC1A.png 472 × 472; 87 KB
- TC1B.png 531 × 531; 70 KB
- TC2.jpg 472 × 472; 54 KB
- TC3.jpg 591 × 592; 108 KB
- TC4.jpg 591 × 592; 116 KB
- TC5.jpg 591 × 591; 123 KB
- TD0.png 531 × 531; 65 KB
- TD1.png 472 × 472; 73 KB
- TD1A.png 472 × 472; 98 KB
- TD2.jpg 492 × 472; 46 KB
- TD2A.jpg 472 × 472; 45 KB
- TD3.jpg 591 × 591; 96 KB
- TD4.jpg 295 × 295; 71 KB
- TD5.jpg 295 × 295; 63 KB